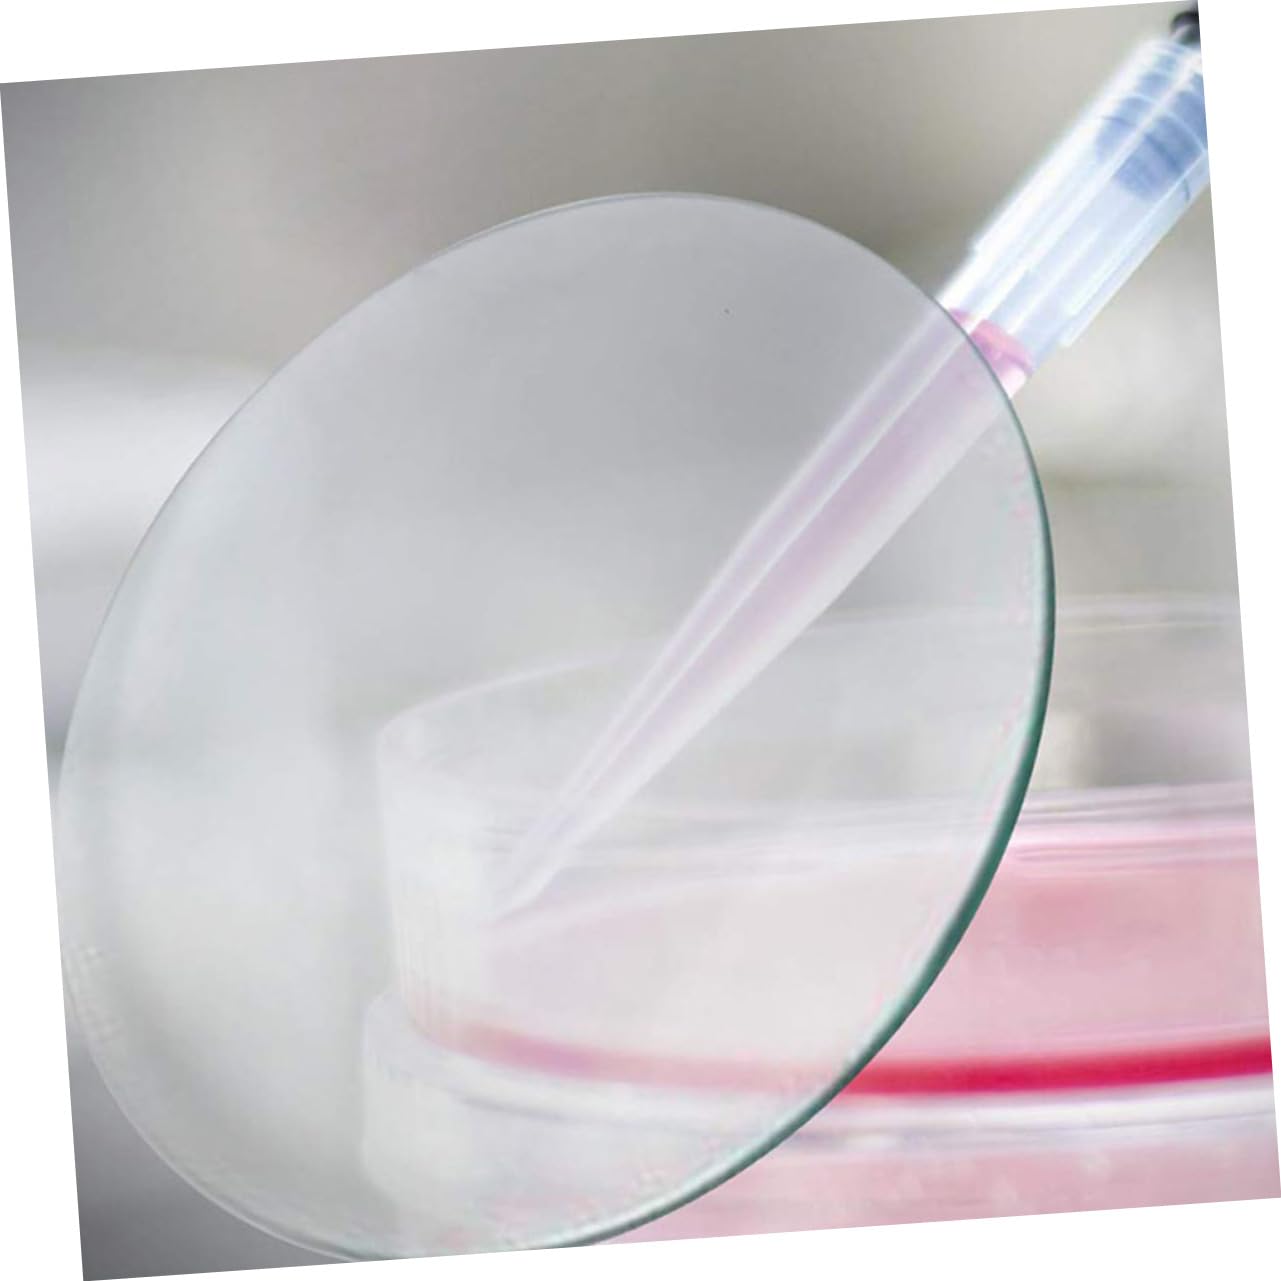
VILLFUL 10pcs Glassware Beakers Cover Labs Chemistry Beaker Cover Watch Glasses Lab Instruments Equipment Lab Utensils Beakers Cover for Chemistry Experiment Laboratory Cover Transparent

Product Information
Specification
Brand : VILLFUL
BulletPoint1 : Laboratory glass accessories-- after careful polishing, the surface is smooth and burr- , , and ,chemical experiment glass
BulletPoint2 : Chemistry beaker cover-- it has a wide range of uses and can be used for the mixing of experimental liquids, the storage of samples and the lid of the beakers,teaching watch glass
BulletPoint3 : Watch glass-- good for science experiment enthusiasts, testing institution, laboratory, chemistry classroom and more uses,transparent watch glass
BulletPoint4 : Glass-- proper for many places like school, laboratory and industry to use, easy to take to anywhere you need,laboratory watch glasses
BulletPoint5 : Chemistry beakers cover-- the ground edges and polished surface provides a safe product for handling in the classroom or laboratory,beakers cover labs
Color : Transparent
ItemDisplayDimensions_Length : 3.94 centimeters
ItemDisplayWeight : 0.55 pounds
ItemName : VILLFUL 10pcs Glassware Beakers Cover Labs Chemistry Beaker Cover Watch Glasses Lab Instruments Equipment Lab Utensils Beakers Cover for Chemistry Experiment Laboratory Cover Transparent
ItemPackageDimensions_Height : 3.94 inches
ItemPackageDimensions_Length : 4.72 inches
ItemPackageDimensions_Width : 4.72 inches
ItemTypeKeyword : science-lab-watch-glasses
ItemVolume : 1 cubic_centimeters
Manufacturer : VILLFUL
Material : glass
ModelNumber : 51436112WG
NumberOfItems : 1
NumberOfLithiumMetalCells : 1
PartNumber : 51436112WG
ProductDescription : Package List
10 x watch glasses
Features
-Color:Transparent Laboratory Glass Accessories
-Size:10.00X10.00X0.20cm/3.93X3.93X0.08in toys
-Material:Glass slides
- Made of glass materials, and , you can use with peace of mind Teaching Watch Glass.
- Transparent, round and flat shape, sturdy, not easy to deform for long time to use Watch Glass.
- Good for science experiment enthusiasts, testing institution, laboratory, chemistry classroom and more uses cover set.
- Exquisite craftsmanship ensure its durability and practicality, offering you satisfying using experience stuff.
- It can be evaporating dish, also beakers cover, and also, the watch glass can be used as load carrier evaporating dish cover.
Goods Description
Beakers Cover for Chemistry Simple structure with stable working performance, easy to use, let the fluid surface area increased, accelerate evaporation.Glass Beakers Cover Made of glass materials, and , they are helpful tools for laboratory teaching, school, chemical experiment supply.Watch Glasses for School These are some watch glasses for laboratory use, can be used to do some evaporation of liquid, also can be beakers cover
ProductSiteLaunchDate : 2024-10-15T04:30:22.540Z
Size : 10x10cm
SupplierDeclaredDgHzRegulation : not_applicable